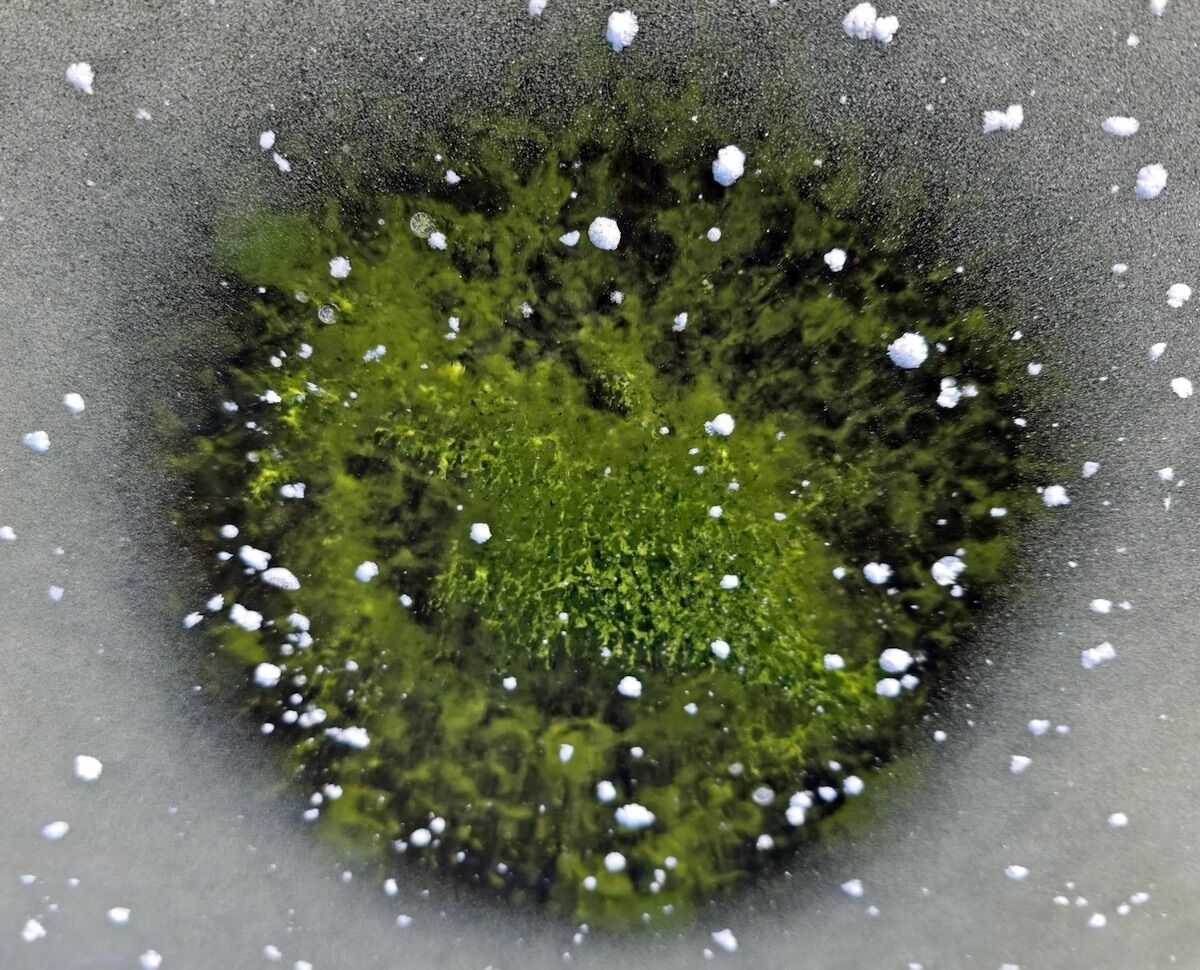
Toxic algae turned an icy lake emerald green

Petr Znachor / BC CAS

Green ice on Lake Lipno caused by cyanobacteria in December 2025
Climate change and pollution are making rare winter blooms of cyanobacteria more common.
In the Czech Republic, the emerald-green ice of a frozen lake is providing biologists with an unprecedented opportunity to study a strange — and unsettling — natural phenomenon.
At the end of 2025, researchers from the Czech Academy of Sciences (CAS) traveled to Lake Lipnoin South Bohemia, to collect and examine samples of an unusual proliferation of cyanobacteria in the middle of winter.
Its findings could help to better understand a problem that threatens both local marine life and nearby human populations, says .
Like many bodies of water, Lake Lipno is no stranger to cyanobacteria. To the photosynthetic blue-green algae They typically thrive during the warmer summer and fall months, particularly in environments with excess nutrients — a process known as eutrophication.
Cyanobacteria blooms are notoriously fetidbut the real problem is the damage they cause to local ecosystems. Each bloom produces exponentially growing waves of cyanotoxins that can poison and even kill nearby aquatic organisms.
Petr Znachor / BC CAS

Cyanobacteria frozen in ice, with visible oxygen bubbles that reveal active photosynthesis
Unfortunately, these episodes are increasing due to climate change and human pollution, particularly industrial phosphorus runoff.
“The green ice on Lake Lipno falls within the long-term changes which we observe here in connection with the eutrophication and climate change ongoing”, says the hydrobiologist Petr Znachor in one of CAS. “This suggests that we may witness similar surprises more frequently in the future.”
In most freshwater reservoirs in the Czech Republic, cyanobacteria blooms usually disappear by the end of September. However, Lake Lipno has long recorded longer algae seasons.
Marine biologists have repeatedly documented sizable populations of cyanobacteria lasting through November and, occasionally until December or even January.
Similar conditions in late 2025 allowed a biomass of algae to remain near the lake surface until the water starts to freeze. According to researchers, weeks of sunshine, calm weather and windy conditions favorable conditions were probably responsible.
In their research, researchers from the Czech Academy of Sciences also confirmed that their field samples contained the common species of cyanobacteria Woronichinia naegeliana.
Although the thin layer of ice was itself transparent, the cyanobacteria maintained their characteristic green colorwhich could be easily seen from the bank and from above. A brief period of warmer weather near December 24th melted some of the ice, which then refroze.
Differences in the absorption of solar radiation allowed these new patches of transparent ice to develop over darker areas of algae, forming what is called “cyanobacteria eyes“.
Petr Znachor / BC CAS
The “eyes of cyanobacteria” — zones of clear ice above dark algal formations
The bloom only disappeared after a heavy snowfall finally blocked enough light to prevent it from reaching it under the ice.
It is not known for sureHow these winter icy blooms will affect their ecosystems, but unfortunately similar incidents are almost certain to become more common — both in Lake Lipno and in other waters around the world.